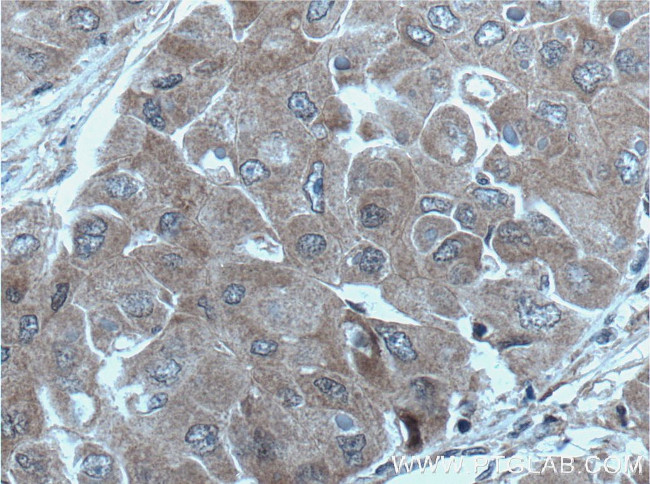
UBE2S Antibody in Immunohistochemistry (Paraffin) (IHC (P))
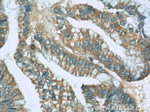
UBE2S Antibody in Immunohistochemistry (Paraffin) (IHC (P))

Search
Proteintech
UBE2S Polyclonal Antibody
{{$productOrderCtrl.translations['antibody.pdp.commerceCard.promotion.promotions']}}
{{$productOrderCtrl.translations['antibody.pdp.commerceCard.promotion.viewpromo']}}
{{$productOrderCtrl.translations['antibody.pdp.commerceCard.promotion.promocode']}}: {{promo.promoCode}} {{promo.promoTitle}} {{promo.promoDescription}}. {{$productOrderCtrl.translations['antibody.pdp.commerceCard.promotion.learnmore']}}
产品信息
14115-1-AP
种属反应
已发表种属
宿主/亚型
分类
类型
抗原
偶联物
形式
浓度
规格
纯化类型
保存液
内含物
保存条件
运输条件
产品详细信息
Immunogen sequence: MNSNVENLP PHIIRLVYKE VTTLTADPPD GIKVFPNEED LTDLQVTIEG PEGTPYAGGL FRMKLLLGKD FPASPPKGYF LTKIFHLNVG ANGEICVNVL KRDWTAELGI RHVLLTIRCL LIHPNPESAL NEEAGRLLLE NSEEYAARAR LLTEIHGGAG GPSGRAEAGR ALASGTAASS TDPGAPGGLG GAEGPMAKKH AGERDKKLAA KKKTDKKRAL RRL (1-222 aa encoded by BC066948)
靶标信息
This gene encodes a member of the ubiquitin-conjugating enzyme family. The encoded protein is able to form a thiol ester linkage with ubiquitin in a ubiquitin activating enzyme-dependent manner, a characteristic property of ubiquitin carrier proteins.
仅用于科研。不用于诊断过程。未经明确授权不得转售。
生物信息学
蛋白别名: E2 ubiquitin-conjugating enzyme S; E2-EPF; E2-EPF5; Ubiquitin carrier protein S; ubiquitin conjugating enzyme E2S; Ubiquitin-conjugating enzyme E2 S; Ubiquitin-conjugating enzyme E2-24 kDa; Ubiquitin-conjugating enzyme E2-EPF5; Ubiquitin-protein ligase S
基因别名: 0910001J09Rik; 6720465F12Rik; AA409170; E2-EPF; E2EPF; EPF5; OK/SW-cl.73; RGD1564746; UBE2S
UniProt ID: (Human) Q16763, (Rat) B5DFI8, (Mouse) Q921J4
Entrez Gene ID: (Human) 27338, (Rat) 292588, (Mouse) 77891